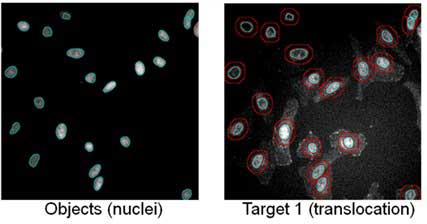

近年、細胞生物学分野のさまざまな研究は、数々の病態に対する新しい治療法の検索に重要な技術としてさらなる注目を集めています。弊社の細胞イメージアナライザーは、細胞撮影画像から各種情報を数値化することにより、定量的で客観的な細胞解析(HCA/HCS)を可能とする測定機器です。前々回と前回はこの細胞イメージアナライザーの解析技術と概要、アプリケーションを紹介いたしました。今回も引き続き、実際の解析アプリケーションについて紹介いたします。
今回は、次回との2回に渡り、細胞内で機能している多数のシグナル伝達経路の中で、細胞の癌化・生存とアポトーシスの調整に重要な役割を演じているAKTシグナルパスウェイの解析事例をご紹介いたします。
はじめに
細胞の中では、多くのシグナルパスウェイが細胞運命決定「Cell fate」に関与していますが、その多くはPI3K(ホスファチジルイノシトール3-キナーゼ)-AKT(プロテインキナーゼB)-mTOR(哺乳類ラパマイシン標的蛋白質)経路を介するシグナルパスウェイに集中しており、その中でも重要な役割を担うAKTは細胞のマスターレギュレータの役割を担っています。
AKTに限らず、細胞内のパスウェイの変化は、ターゲットとなる蛋白質が複数存在すること、そしてそれらキーとなる蛋白質群の活性化のターンオーバーが短いことから、今までのアッセイ系では容易に測定ができませんでした。細胞イメージアナライザーがもたらす細胞ベースのHCAは、一つ一つの細胞ごとに複数の目標蛋白質の活性化状態、およびその細胞内での存在部位の両方を同時にモニターできるという点で、従来のアッセイよりも優れた解析手法であるといえます。
今回の事例では、AKTシグナルパスウェイにおける、AKTおよびその下流のエフェクターであるGSK3、FOXO1Aの活性化状態の測定、および核内/細胞質内の存在量比をHCAで定量的に測定した結果を示します。
細胞内分子の検出方法
測定には3T3 L1細胞を用い、IGF-1処理またはLY294002(AKT阻害剤)処理後、核染色およびターゲット蛋白質(リン酸化AKTなど)を抗体染色したサンプルを作成しました。細胞イメージアナライザーを用いてこれらサンプルの蛍光画像を取得し、細胞一つ一つの核領域、細胞質領域をそれぞれセグメント(形状認識)することで、ターゲット蛋白質の活性化状態の測定、および核内/細胞質内の存在量比を画像から定量化しました。
図1 核領域および細胞質領域のセグメント(形状認識)例。 核染色の画像から、核領域をセグメントし(図左、核染色画像の青緑のライン)、その周囲にリング状の領域を定義し、細胞質領域として解析を行いました(図右、ターゲット蛋白質染色画像の赤のライン)。
リン酸化AKTの用量反応曲線
図2はIGF-1処理によるAKTリン酸化反応を蛍光画像として捉えたものです。細胞イメージアナライザーにより、細胞の蛍光画像から、細胞一つ一つの核領域、細胞質領域にある蛍光抗体の発する蛍光強度を測定し、核内/細胞質内の蛍光強度比からリン酸化AKTの存在量比を測定し、用量反応曲線を作成、半数影響量を算出できました。

図2 AKTリン酸化反応の蛍光画像と用量反応曲線。 A) 3T3 L1細胞の蛍光画像。細胞は成長因子枯渇培地中で終夜培養され、その後200 ng/mlのIGF-1で30分処理されました。処理後の細胞は固定化され、核染色およびリン酸化AKT1次抗体-蛍光2次抗体を使用して蛍光染色されました。B) さまざまな濃度のIGF-1によって処理された3T3 L1細胞のリン酸化AKT用量反応曲線。実験は3枚のプレート使って行われました。グラフ横軸はIGF-1処理濃度、縦軸はリン酸化AKTの核内/細胞質内の存在量比を数値化したものです。グラフ下にEC50の値を示しています。
いかがでしたでしょうか?
次回は、リン酸化GSK3の用量反応曲線についての解析、およびFOXO1Aの核内局在変化についてご紹介いたします。
細胞解析・細胞イメージに関するお問い合わせについて
細胞解析機器について
- デモを依頼したい
- 見積もりがほしい
- その他(資料がほしい、話を聞いてみたい、担当者から連絡がほしい 等)
等のご要望がありましたら、下記ボタンよりお気軽にご相談ください。
研究用にのみ使用できます。診断目的およびその手続き上での使用はできません。



